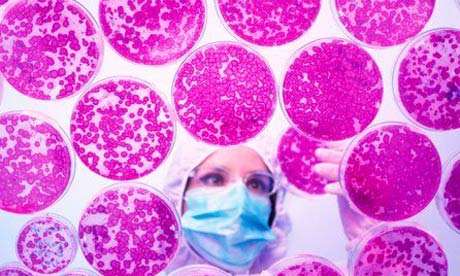
Stem cells being grown in a petri dish BHF

Picture this. The new chair of the Arts Council is walking across the stage at SOTA 13, ready to deliver his or her very first (and no doubt) very digital keynote speech. Suddenly a switch flips, the cavernous theatre darkens and instead of a bland lectern we are looking at a stage transformed by an extraordinary projection of the Lincoln Memorial.
The crowd are hushed, gazing up the digital illusion. The speaker, whose white lycra onesie is now transformed into an iconic sleek black suit and tie, taps the mike. Marble columns ripple on either side, Lincoln's enormous knee shimmers.
"I have a database." A murmur of confusion. What was that? Shouldn't that be "a dream"?
It may sound mad but if I had my way the new chair's reign would start precisely like this. Why? Firstly, because projection is cool. Secondly, because if the arts are really going to move forward and take advantage of the digital age, they might need to invest in that most neglected bit of kit: the database.
If you attend any arts conferences these days you'll be treated to a parade of digital know-it-alls, marching up and down in front of sick-inducing presentations and bleating two words. Innovate, they say. Collaborate, they drone. The audience invariably has one word in response. How?
The answer is simple enough: the time might just have come for an ambitious, shared database. Imagine every cultural organisation using one system to capture their back office, web and marketing performance, then converting that data into useful insights for other sector activities.
Take two key species of data in an arts organisation – box office and donor data – often trapped in two different databases when the former could inform the latter hugely. In the age of the API there is no excuse for this.
But why stop there? Let's stitch all the data types together. We could track ticket purchasers, measure and map audiences, note accounts, compare web analytics, monitor social, share data, share donors.
Imagine the questions we could start to answer. What time of day do people buy tickets online? What age do they start to give? What areas of the country respond to what web layout? Imagine the lifelong picture of arts audiences we could start to build.
Collating and distributing this information would be child's play in a shared system and, the thing is, most of it is already built. At the core we would need a sophisticated Cloud-based platform onto which we could knit specialist databases like Raiser's Edge.
Yes. You could use Tessitura for one, a specialist cultural database, or even the campaigning database Nationbuilder that incorporates social media in a very sophisticated manner. Another option could be Salesforce, the evolving database platform used by businesses worldwide, including the Guardian.
Multinationals across the globe weave their activities together using it, wrangling the data to create snapshots of their performance. Intriguingly Salesforce recently purchased Radian 6, the social media cruncher. The platforms will surely mingle, giving the arts the means to compute social data on a large scale.
Whatever route we choose, building a coherent system that mapped, captured, then mixed the data could be achievable. The part we would have to build, the new bit, would be the report generator that extrapolated data from one activity to make it useful for another. This would be custom built and open source, allowing for improvement as we go and perhaps inspired by data collection other sectors are embarking on.
Of course we would have to hire a team of data wranglers, or even an arts data tsar to analyse and make this data useful – that or feed it through to a company like Dunnhumby, who create customer insights for large corporations.
Then again, why just give it away? A really intriguing economic option opens up with big data, especially if you agree with this new cliché that data is the new oil. The arts could sell its data to marketing or internet search firms the way Songkick sell to Yahoo. Imagine that? A capitalistic resource fuelling experimental art.
So far so good. We have created a shareable megabase and the arts are collecting data by the bucket. The thing is, there are a few problems. Yes, there are arts organisations that share back office systems but nothing so comprehensively ambitious as this, one system for all.
Have other sectors tried something like it and failed horribly? Yes, the NHS for one. Privacy of course is another minefield. The information would have to be thoroughly anonymised, a task in itself and perhaps a block to incorporating data from new payment systems that may emerge like 'wave and pay'.
Then of course there is the issue of competition. Is the theatre down the road a fellow data pilgrim or simply a competitor? Are we prepared as a sector to share so deeply? Forget Digital Twinning; this would be complete fusion. Forget The Starfish and the Spider, this would herald the age of the slime mould, that curious creature so often referenced in digital thinking.
Still, whatever the issues a unified system that collects multiple data streams is an intriguing possibility. For the first time we would begin to collect big data on the UK arts, taking a digital and evolving impression of the relationship culture has with the country.
Given time to mature, it could mean more than shared information – it could in effect become a heart monitor, telling us not just how we are doing but where to go next.
We could even give this project a name. Considering all the stitching involved perhaps #FrankenBase would work. If you are already doing something like this or want a say on how it would work, comment or tweet away.
Patrick Hussey is digital campaigns manager at Arts & Business – follow him on Twitter @arts_business and @PatrickRiot
This content is brought to you by Guardian Professional. To get more articles like this direct to your inbox, sign up free to become a member of the Culture Professionals Network.







